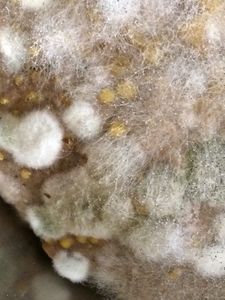

CONSORTIUM OF FUNGI ON FERMENTED DOUGH
 Jan 02, 2019 • 8:59 AM UTC
Jan 02, 2019 • 8:59 AM UTC Unknown Location
Unknown Location 140x Magnification
140x Magnification Microorganisms
Microorganisms
jasveen dua
Learn about the author...
22posts
1comments
1locations

View in Media Gallery
My winter vacations began with fungal rich samples for my
foldscope. Travelling from Chandigarh to Ahmedabad (in Gujarat) to my
daughter’s place proved to be an enthusiastic vacation for me. While she was
off to her workplace, I was busy cleaning the mess and there I got samples
worth to view under a foldscope.
In a corner of the kitchen lay a bowl of fermented dough
with fungal growth on it. On the grey-black velvety mat I could see some pure
white cottony colonies. I took a slide and fixed a little sample to see through
my foldscope. A neat, woven, intricate network of hyphae could be seen. I tried
hard to locate spores or sporangia, but very tiny structures could be seen.
foldscope. Travelling from Chandigarh to Ahmedabad (in Gujarat) to my
daughter’s place proved to be an enthusiastic vacation for me. While she was
off to her workplace, I was busy cleaning the mess and there I got samples
worth to view under a foldscope.
In a corner of the kitchen lay a bowl of fermented dough
with fungal growth on it. On the grey-black velvety mat I could see some pure
white cottony colonies. I took a slide and fixed a little sample to see through
my foldscope. A neat, woven, intricate network of hyphae could be seen. I tried
hard to locate spores or sporangia, but very tiny structures could be seen.

I took another sample from the same dough, this time of the
grey-black velvety growth. Seeing closely, I could see some white pin head-like
structures. Under a foldscope long stalked sporangiophores with sporangia
hanging on them were clearly seen. Even the emergence of sporangia on the
rounded tips of the sporangiophores was a treat to the eyes.
The greed in me forced to have yet another sample fixed on
the slide. This time I took both the white as well as greyish mat. I was
astonished to see a consortium of fungi. Now I could clearly make out:
Black mould with long prominent, thick, aseptate hyphae with sporangia at the tips Thin, fine, network of hyphae forming a cross-weaving pattern and granulated cytoplasm Fusiform, multi-cellular conidia forming chains at some loci could be seen emerging from branched hypha. Probably the dough was left outside since long giving space for many fungi to grow together.
grey-black velvety growth. Seeing closely, I could see some white pin head-like
structures. Under a foldscope long stalked sporangiophores with sporangia
hanging on them were clearly seen. Even the emergence of sporangia on the
rounded tips of the sporangiophores was a treat to the eyes.
The greed in me forced to have yet another sample fixed on
the slide. This time I took both the white as well as greyish mat. I was
astonished to see a consortium of fungi. Now I could clearly make out:
Black mould with long prominent, thick, aseptate hyphae with sporangia at the tips Thin, fine, network of hyphae forming a cross-weaving pattern and granulated cytoplasm Fusiform, multi-cellular conidia forming chains at some loci could be seen emerging from branched hypha. Probably the dough was left outside since long giving space for many fungi to grow together.














Sign in to commentNobody has commented yet... Share your thoughts with the author and start the discussion!

 0 Applause
0 Applause 0 Comments
0 Comments

















